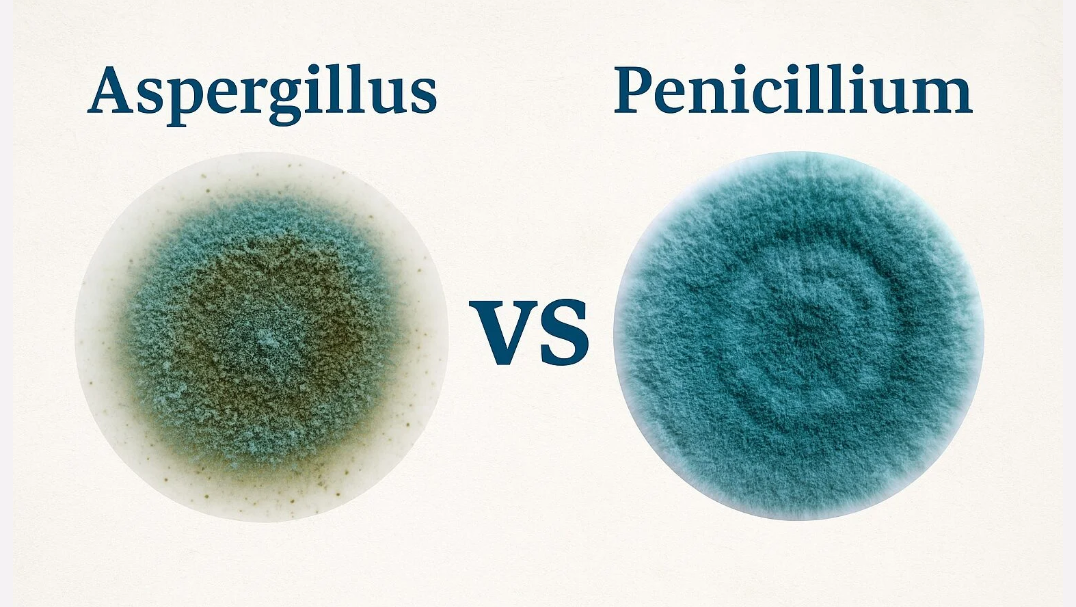

Introduction to Aspergillus vs Penicillium Mold
Many homeowners are surprised to learn that not all mold types are the same. Among the most common indoor molds found in Miami properties are Aspergillus and Penicillium. Understanding Aspergillus vs Penicillium mold is essential because both grow quickly in humid climates and can affect air quality, structural materials, and overall health. Miami’s warm and moist environment allows these molds to thrive, especially in hidden areas like attics, basements, crawlspaces, and HVAC systems. As a result, services from the best air duct cleaning company and professional mold remediation become essential to maintain healthy indoor spaces. Whether it is mold removal in Coral Gables, mold removal in Fisher Island, or mold remediation in Brickell, homeowners benefit from knowing what sets these mold types apart.
What Is Aspergillus Mold
Aspergillus is a common indoor mold that grows in dust, damp surfaces, insulation, and air conditioning systems. It spreads easily through airborne spores and may trigger allergy like symptoms in sensitive individuals. This mold often appears in yellow, green, brown, or black shades, depending on the species. Many types of Aspergillus can survive in low nutrient environments, which makes them difficult to eliminate without professional help. When evaluating Aspergillus vs Penicillium mold, one key difference is that many strains of Aspergillus can grow in both dry and moist areas. This makes regular inspections and proper ventilation important, along with support from the best air duct cleaning company to avoid spores circulating indoors.
What Is Penicillium Mold
Penicillium is another very common mold found inside homes and commercial buildings. It spreads rapidly and produces a distinctive blue or green appearance. Penicillium prefers moist environments and often grows after water damage, plumbing leaks, and high humidity conditions. It is especially common in carpets, wallpaper, drywall, and soft furnishings. Penicillium spreads quickly and releases spores that easily travel through ventilation systems. This is why combining mold remediation with professional duct cleaning provides a complete solution for indoor air purity. When comparing Aspergillus vs Penicillium mold, Penicillium is more commonly associated with water damaged materials and may grow aggressively when moisture is present.
Key Differences in Aspergillus vs Penicillium Mold
Although both molds appear in many homes around Miami, they have important differences.
Growth Conditions
Comparing Aspergillus vs Penicillium mold shows that Aspergillus can grow in dry and damp areas, while Penicillium thrives mostly in moist, water damaged environments.
Appearance
Aspergillus may appear in shades of yellow, brown, black, or green.
Penicillium is often bright green or blue with a powdery texture.
Spread and Migration
Both molds spread through airborne spores, but Penicillium tends to travel faster across surfaces, while Aspergillus spreads strongly through the air and HVAC systems.
Health Effects
Both molds can cause respiratory symptoms, but Aspergillus includes species that potentially trigger more severe reactions in sensitive individuals.
Understanding these differences helps homeowners and businesses respond quickly and appropriately when mold is discovered.
Why Miami Homes Commonly Experience These Molds
Miami’s environment creates the perfect conditions for mold. High humidity, heavy rain, coastal influence, and warm temperatures contribute to rapid mold growth. This is why mold removal in Coral Gables, mold removal in Fisher Island, and mold remediation in Brickell are consistently needed services. Properties in these areas often face challenges such as aging structures, poor ventilation, and recurring moisture exposure. Without proper maintenance, Aspergillus vs Penicillium mold can develop and spread within days.
Air ducts are another major source of moisture and contaminants. When the HVAC system collects dust and humidity, mold spores attach and multiply. This makes the best air duct cleaning company an important partner for keeping indoor air clean and safe.
How the Best Air Duct Cleaning Company Helps Prevent Mold Spread
Air ducts act like a highway for mold spores. If left uncleaned, they circulate contaminants throughout the home or workplace. The best air duct cleaning company uses specialized equipment to remove dust, debris, and mold buildup that may be hiding inside the ventilation system. This helps improve airflow, reduce odors, and prevent mold from returning after remediation.
Professional duct cleaning plays a major role when tackling issues related to Aspergillus vs Penicillium mold because these spores easily travel through vents. Regular cleaning reduces exposure and keeps the environment healthier. This also supports long term prevention, especially in humid regions like Miami.
Professional Mold Removal and Remediation Services
Homeowners in South Florida benefit from partnering with experts who understand the habits of Aspergillus vs Penicillium mold. Mold removal in Coral Gables often involves detailed inspections to identify hidden growth. Mold removal in Fisher Island requires precision and high quality techniques due to luxury interiors. Mold remediation in Brickell focuses on high rise challenges and HVAC related moisture.
Professionals follow several steps to remove mold safely:
- Complete mold detection and testing
- Containment to stop the spread of spores
- Air purification using HEPA filtration
- Safe removal of damaged materials
- Antimicrobial cleaning of affected areas
- Moisture control and prevention measures
These steps help ensure long term protection and healthier air for families and businesses.
Benefits of Understanding Aspergillus vs Penicillium Mold
Knowing the differences between these mold types helps property owners respond faster and choose the right services. Benefits include:
- Better prevention strategies
- Improved indoor air quality
- Faster identification of mold type
- More effective remediation
- Lower chance of recurrence
- Safer living and working environments
When combined with services from the best air duct cleaning company, homeowners gain full indoor protection from moisture and airborne mold spores.
Frequently Asked Questions (FAQs)
1. What is the main difference between Aspergillus vs Penicillium mold
The main difference is that Aspergillus grows in both dry and wet areas, while Penicillium grows mostly in moist environments.
2. Which mold spreads faster
Penicillium spreads rapidly across surfaces, while Aspergillus often spreads through the air and HVAC systems.
3. Can these molds make indoor air unhealthy
Yes, both molds release spores that can affect breathing and indoor air quality.
4. How can I prevent mold from returning
Fixing moisture problems and hiring the best air duct cleaning company helps prevent mold from returning.
5. Do Miami homes get these molds often
Yes, Miami’s humid climate makes homes more likely to develop Aspergillus vs Penicillium mold problems.

Comments